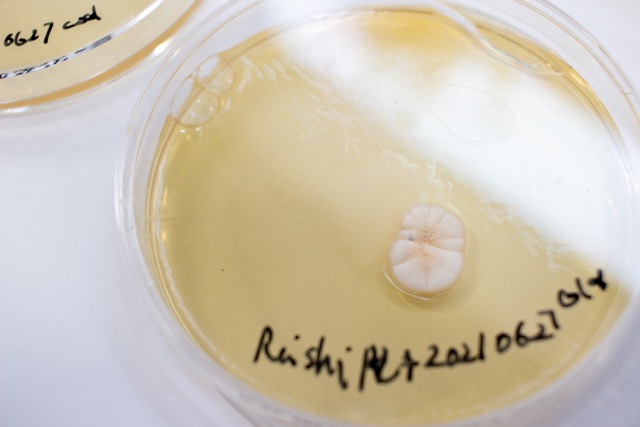

Apr. 2021 – Feb. 2022
Keywords: Alternative Reality, Biomaterial, Mending, Locality, Circularity
The project features a worn-down running shoe mended by mycelium. My research began by questioning the trend of using biomaterials for the production and consumption of new products while there is a lack of care for existing products. The detailed documentation of the research process and the playful yet critical outcomes, i.e. our “belongings” coming alive as mycelium weaves itself into and becomes one with a shoe, brings about a new perspective of care.

Mycelium has been receiving much attention as the new sustainable material to create products such as shoes. However, the world is already saturated with shoes; many of them will remain with us for centuries as they are made from synthetic materials which are difficult to decompose. Why are we so focused on making even more? Can’t we prolong the life of the already existing products by repairing/mending them rather than throwing them into landfill or burning them and buying new ones?
What if we mend our shoes together with mycelium? What will it mean to care for our belongings? How will our lifestyle change if we invite mycelium into the practice of mending as a daily practice? The project “Mending with Mycelium” explores these questions through material research on the possibility of mycelium as a material for and partner in mending, and a near-future scenario based in Kyoto, Japan about a Kinji-ya or co-mender, a professional who mends shoes in collaboration with mycelium.
For the outcome of the project, I created a method to repair the worn-down soles of sneakers. Specifically, a new layer of mycelium composite is grown directly onto the sneaker. Through material research, I found that the mycelium weaves itself into woven textiles. In my early tests mycelium easily broke down natural fibers such as silk and cotton as it is a decomposer. However, textiles made of synthetic fibers stay practically the same and the mycelium just grew in and out of them, like when you darn a sweater. This is where I got my inspiration for the project. The shoe needing repair is 3D scanned and a reusable mold is 3D printed. The cleaned shoe is placed in the mold and the mycelium substrate is filled in the spaces. Within about two to three weeks, the mycelium grows into the shape of the new sole and weaves itself into the upper of the sneaker fastening itself onto the whole sneaker.

1. Material Research & Development
I developed a method to invite mycelium into the practice of mending worn-down sneaker soles. The idea came about from my findings of mycelium weaving itself through synthetic textile and creating a new surface similar to darning.

2. Alternative Reality Research & Development
2-1. Human-Mushroom Relations
Many magical stories about mushrooms exist around the world. I found that mushrooms often have agency in Japanese folk stories.


2-2. Local Materials of Kyoto City
Almost all materials for mending with mycelium can be found within a 20km radius. The wood chips, the rice husk and the mushroom. The PLA filament for the 3D printing would be the challenge.


*1: Tetsuya Maeoka. “The Big Book of Monsters – No.22004: The Bakemono Mushroom.” News Wakayama, News Wakayama, 3 Apr. 2021
*2: Manga Nihon Mukashi Banashi (The Old Japanese Story) “The Haunted Shimeji” Air Date: November 21, 1992 Drawing: Kosei Maeda
*3: July 10, 2021 – A hiker showed me a photo of a Reishi he found that day I went mushroom hunting to Takaragaike for research. Reishi is a strong mushroom which I used for the research.
*4: Map of Kyoto, google maps
3. Proposal of Alternative Reality
3-1. Picture book “The Kinjiya and Mycelium”
Based on my research I wrote a story on the daily life of a 「菌治屋」 (“Kin-ji-ya”), a professional who collaborates with mycelium to mend objects and created a picture book to communicate it to a wide audience.
Read the full version on issuu.


3-2. Tools and recipe for Mending with Mycelium
I designed tools and a recipe for the 「菌治屋」 (“Kin-ji-ya”) to mend with mycelium.
The mold for the new sole is designed to fit the sneaker by 3D scanning the sneaker and 3D printed with PLA filament. Additionally, the mold is printed in four parts to be disassembled and cleaned to be used many times. The recipe is based on the and literature and my experiments in the biomaterial lab.




